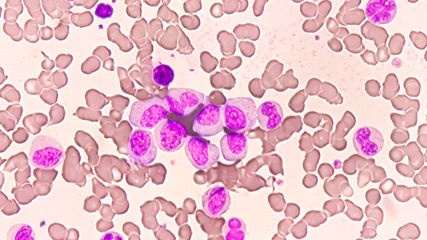

Hautmanifestationen bei onkologischen Erkrankungen
Bericht:
Angelika Bauer-Delto
Sie sind bereits registriert?
Loggen Sie sich mit Ihrem Universimed-Benutzerkonto ein:
Sie sind noch nicht registriert?
Registrieren Sie sich jetzt kostenlos auf universimed.com und erhalten Sie Zugang zu allen Artikeln, bewerten Sie Inhalte und speichern Sie interessante Beiträge in Ihrem persönlichen Bereich
zum späteren Lesen. Ihre Registrierung ist für alle Unversimed-Portale gültig. (inkl. allgemeineplus.at & med-Diplom.at)
Krebserkrankungen verschiedener Organsysteme können auch mit Symptomen an der Haut einhergehen, die manchmal bereits als frühe Warnzeichen auftreten. Dazu zählt ausgeprägter Pruritus. Auch Paraneoplasien können sich entwickeln oder das Risiko für zusätzlichen Hautkrebs kann erhöht sein. Zudem sind im Rahmen von onkologischen Therapien kutane Nebenwirkungen wie das Hand-Fuss-Syndrom möglich. Solche Hautveränderungen bedeuten oft eine Herausforderung.
Keypoints
-
Bei einem Pruritus ohne Hautläsionen sollte an onkologische und andere internistische Grunderkrankungen gedacht und eine Abklärung in die Wege geleitet werden.
-
Verschiedene Hautveränderungen können auf Paraneoplasien hinweisen, die mit Tumorerkrankungen assoziiert sind.
-
Bei einer chronischen lymphatischen Leukämie sowie einer Immunsuppression nach Organtransplantation sollte das erhöhte Risiko für nichtmelanozytären Hautkrebs beachtet werden.
-
Bei Organtransplantierten sind Proliferation und Akantholyse von aktinischen Keratosen Risikofaktoren für die Entwicklung eines Plattenepithelkarzinoms.
-
Dermatologinnen und Dermatologen sollten auch mit Nebenwirkungen onkologischer Therapien an der Haut vertraut sein.
Verschiedene innere Erkrankungen wie nephrologische, endokrine oder gastrointestinale Krankheiten können mit Hautveränderungen assoziiert sein. Auch bei onkologischen Erkrankungen unterschiedlicher Organsysteme kann es zu Manifestationen an der Haut kommen. Viel dermatologische Expertise sei gefragt, um solche Hautveränderungen erkennen und adäquat behandeln zu können, berichtete Prof. Dr. med. Thomas Dirschka, CentroDerm-Klinik Wuppertal, anlässlich des Derma Updates in Mainz/D. Manchmal können Hautveränderungen auch erste Warnzeichen sein und auftreten, noch bevor die assoziierte Grunderkrankung bekannt ist.
Dermatologinnen und Dermatologen können dann einen wichtigen Beitrag zur Früherkennung leisten, indem sie eine sorgfältige Abklärung in die Wege leiten, so Dirschka.
Pruritus ohne Hautläsionen umfassend abklären
Pruritus zählt zu den häufigsten Zuweisungsgründen in die Dermatologie. Bei starkem chronischem Pruritus ohne Hautläsionen sei stets an einen Morbus Hodgkin zu denken, empfahl Dirschka. Pruritus trete bei knapp einem Drittel der an einem Morbus Hodgkin Erkrankten auf und könne der Diagnose viele Monate vorausgehen. Die Abklärung kann langwierig sein, wie der Experte an einem eigenen Fallbeispiel demonstrierte: Ein älterer Patient, der sich mit ausgeprägtem generalisiertem Juckreiz vorstellte, wurde zunächst hämatoonkologisch abgeklärt, jedoch ohne Befund. Erst im Rahmen einer Lungenkontrolle vor Beginn einer Therapie des Pruritus mit Dupilumab wurde ein Morbus Hodgkin im Stadium IV festgestellt.
Darüber hinaus könne sich Pruritus ohne sichtbare Hautveränderungen auch im Rahmen einer chronischen lymphatischen Leukämie entwickeln, erklärte Dirschka.
Aquagener Pruritus, der nach Kontakt mit warmem Wasser auftritt, kann auf eine Polycythaemia vera hinweisen. Auch weitere myeloproliferative Erkrankungen können mit Juckreiz einhergehen.
An Paraneoplasien denken
Tumorerkrankungen können eine Reihe unterschiedlicher Paraneoplasien1 hervorrufen. Diese werden im Praxisalltag oft übersehen oder nicht erkannt, berichtete Dirschka. Bei einer Reihe von Hautveränderungen sollte an eine Paraneoplasie gedacht und – sofern die Grunderkrankung noch nicht bekannt ist – ein Check auf eine assoziierte Tumorerkrankung in die Wege geleitet werden.
Obligate Paraneoplasien mit Tumoren assoziiert
Zu den obligaten Paraneoplasien, die von Tumorerkrankungen ausgelöst werden und nicht unabhängig davon auftreten, zählt die Acrokeratosis psoriasiformis Bazex (Abb. 1). Diese ist gekennzeichnet durch schuppende Hyperkeratosen, die sich innerhalb weniger Wochen vor allem an den Fingern und Zehen entwickeln und mit diffusen Nagelwachstumsstörungen einhergehen können. Auch eine Lokalisation an Ohren oder Nase ist möglich. Betroffene haben keine Psoriasis- oder Atopiediathese, erklärte Dirschka. Die Hautveränderungen sind mit Plattenepithelkarzinomen verschiedener Organe, vor allem der Lunge, aber auch der Zunge, des Pharynx oder Larynx assoziiert.
Eine weitere obligate Paraneoplasie ist die Acanthosis nigricans maligna. Die stark juckende, graubraune, samtartige Verdickung der Epidermis tritt vor allem im Bereich der Axilla, am Nacken oder periumbilikal auf. Diese Paraneoplasie ist ein Indikator für ein Adenokarzinom des Gastrointestinaltraktes oder seltener von Bronchien, Leber, Uterus oder Mamma.
Der Begriff der «obligaten» Paraneoplasie sei in manchen Fällen jedoch infrage zu stellen, wie Dirschka am Beispiel des Erythema gyratum repens Gammel illustrierte. Dabei handelt es sich um eine girlandenförmige, holzmaserungsartige Hautveränderung am Stamm, die mit einem Karzinom unter anderem an Mamma, weiblichen Genitalien, Pharynx, Ösophagus oder Magen assoziiert ist. Eine strenge Zuordnung zu einem malignen Geschehen sei jedoch nicht immer möglich, so Dirschka. Das Erythema gyratum könne auch bei schweren bakteriellen Infektionen wie der pulmonalen Tuberkulose beobachtet werden.2
Fakultative Paraneoplasien unterschiedlich häufig
Fakultative Paraneoplasien weisen eine variable Koinzidenz mit Krebserkrankungen auf (Tab. 1). «Tripe palms»3 zählen zwar zu den fakultativen Paraneoplasien, sind aber immerhin zu 90 Prozent mit einem Adenokarzinom assoziiert, berichtete Dirschka. Die Bezeichnung sei darauf zurückzuführen, dass die Hautveränderungen an ein Gekröse erinnern. In etwa der Hälfte der Fälle geht die Hautveränderung einer Manifestation der Malignität voran. Daher handle es sich um ein Warnzeichen, das umfassend abgeklärt werden sollte, betonte Dirschka.
Eine weitere fakultative Paraneoplasie ist die akute febrile neutrophile Dermatose. Das klinische Bild ähnelt einer Blasenbildung, die Läsionen fühlen sich jedoch solide an, erklärte der Experte. In der Histologie zeigt sich, dass es sich um ein ausgedehntes Papillarkörperödem handelt, das diffus mit Neutrophilen durchsetzt ist. Zugrunde liegen oft myeloproliferative Erkrankungen, seltener urogenitale Tumoren. Das adulte Xanthogranulom (Abb. 2) ist ein schnell wachsender, gelblicher, fleischiger Tumor, der mit hämatologischen Neoplasien assoziiert sein kann.
Die Liste der Paraneoplasien sei möglicherweise deutlich länger als bislang angenommen, sagte Dirschka. So wurden Fallberichte4 über eine Pityriasis rubra pilaris als Paraneoplasie publiziert. Dabei wurde auf einen engen zeitlichen Zusammenhang zwischen dem Auftreten der typischen klinischen Merkmale der Pityriasis rubra pilaris und die Assoziation zu diversen Malignomen, beispielsweise der Mamma oder der Lunge, sowie mit hämatoonkologischen Krankheiten hingewiesen.
Erhöhtes Hautkrebsrisiko beachten
Mit anderen onkologischen Erkrankungen kann auch Hautkrebs assoziiert sein, berichtete Dirschka. Beispielsweise steigt aufgrund der höheren Lebenserwartung bei chronischer lymphatischer Leukämie das Risiko für sekundäre Primärmalignome, insbesondere für kutane Plattenepithelkarzinome. In einem systematischen Review5 wurden Risiko und klinische Merkmale eines Plattenepithelkarzinoms bei Patientinnen und Patienten mit chronischer lymphatischer Leukämie analysiert. Ausgewertet wurden Daten aus 55 Studien. 3,2 Prozent der an chronischer lymphatischer Leukämie Erkrankten entwickelten ein kutanes Plattenepithelkarzinom. Dabei war das Risiko für Metastasen des Plattenepithelkarzinoms erhöht und lag bei 7,3 Prozent für regionale Lymphknoten und bei 3,8 Prozent für Fernmetastasen. Die Sterblichkeitsrate in Zusammenhang mit einem Plattenepithelkarzinom betrug 11,5 Prozent. Die Plattenepithelkarzinome bei chronischer lymphatischer Leukämie zeigten somit im Vergleich zur Allgemeinbevölkerung ein aggressiveres Verhalten, erwiesen sich aber als weniger aggressiv als bei Organtransplantierten. Bei solchen Risikogruppen riet Dirschka zu engmaschigen Hautkrebs-Screenings und Kontrollen.
Progression aktinischer Keratosen nach Organtransplantation
Nach Organtransplantationen entwickeln sich relativ schnell aktinische Keratosen und Plattenepithelkarzinome, sagte Dirschka. Menschen unter einer immunsuppressiven Langzeittherapie nach einer Organtransplantation haben ein 250-fach erhöhtes Risiko, dass aktinische Keratosen zu invasiven Plattenepithelkarzinomen fortschreiten.
In einer Untersuchung6 seiner eigenen Arbeitsgruppe wurden die Eigenschaften von aktinischen Keratosen bei Organtransplantierten mit denen einer Kontrollgruppe immunkompetenter Personen verglichen, berichtete Dirschka. Es zeigten sich signifikante Unterschiede in der basalen Proliferation und Akantholyse: Aktinische Keratosen von Organtransplantierten wiesen im Vergleich zur Kontrollgruppe eine höhere Rate an basaler Proliferation (80,2 vs. 33,3 Prozent) und Akantholyse auf (59,5 vs. 32,4 Prozent) .
Proliferation und Akantholyse aktinischer Keratosen wurden als potenzielle Risikofaktoren für die Progression und die Entwicklung invasiver Plattenepithelkarzinome identifiziert. Mittels optischer Kohärenztomografie lassen sich diese histologischen Eigenschaften gut darstellen, erklärte der Experte. Klinisch sind solche aktinischen Keratosen oft schmerzhaft bei Berührung, neigen zu Superinfektionen und erweisen sich als schwierig zu behandeln.
Kutane Nebenwirkungen onkologischer Therapien
Dermatologinnen und Dermatologen seien auch bei Hautveränderungen infolge onkologischer Therapien gefragt, sagte Dirschka. Dazu zählt das Hand-Fuss-Syndrom (Erythroästhesie), das als Nebenwirkung bestimmter Chemotherapeutika auftreten kann. Zytostatische Wirkstoffe wie Capecitabin werden über die ekkrinen Schweissdrüsen abgesondert und führen so zu einer Toxizität an Handflächen und Fusssohlen. Ein Hand-Fuss-Syndrom mit schmerzhaften Erythemen und Schwellungen kann die Folge sein.
Empfohlen wird, Hitze und mechanische Belastungen der Hände und Füsse zu vermeiden, sie zu kühlen sowie mit feuchtigkeitsspendenden und harnstoffhaltigen Cremes zu pflegen. Auch topische Kortikosteroide und Schmerzmittel werden angewendet. Aktuelle Studiendaten7 ergaben, dass bei einer Behandlung mit Capecitabin die Anwendung von topischem Diclofenac-Gel eine wirksame Präventionsmassnahme darstellt. Das Risiko für das Auftreten eines Hand-Fuss-Syndroms Grad 2 oder 3 konnte damit signifikant reduziert werden: In der Diclofenac-Gruppe kam es bei 3,8 Prozent zu dieser Nebenwirkung, in der Placebogruppe dagegen bei 15 Prozent.
Monoklonale Antikörper wie Cetuximab, die gegen den epidermalen Wachstumsfaktor-Rezeptor (EGFR) gerichtet sind und zur Krebsimmuntherapie eingesetzt werden, können ein EGFR-Inhibitor-Exanthem hervorrufen. Die papulopustulösen Hautläsionen werden oft fälschlicherweise als akneiform bezeichnet, so Dirschka. Sie ähneln jedoch eher einer Rosazea und sprechen auch auf entsprechende Therapiemassnahmen an, beispielsweise auf niedrig dosiertes Doxycyclin in Kombination mit topischem Ivermectin. Ein neuer Therapieansatz zur Behandlung von EGFR-Inhibitor-induziertem Hautausschlag könnte der topische BRAF-Inhibitor LUT014 werden, der aktuell in einer Phase-II-Studie geprüft wird.
Quelle:
Vortrag von Prof. Dr. med. Thomas Dirschka: «Hot topic: Haut und Innere», anlässlich des 18. Derma Update, Mainz, November 2024
Literatur:
1 Dirschka T et al.: Dermatologie. 4. Auflage. München: Elsevier, 2020 2 Contag CA et al.: Erythema gyratum repens secondary to pulmonary tuberculosis. Ann Int Med 2023; 176(5): 733-5 3 Obermeier PE, Hillen U: Palmar skin changes (tripe palms) - an early paraneoplastic warning sign. Dtsch Arztebl Int 2024; 121(11): 372 4 Davis AE et al.: Rethinking pityriasis rubra pilaris as a paraneoplastic syndrome: Two cases of pityriasis rubra pilaris with concomitant underlying malignancy. JAAD Case Rep 2022; 32: 90-5 5 Lai M et al.: Cutaneous squamous cell carcinoma in patients with chronic lymphocytic leukemia: A systematic review of the literature. Int J Dermatol 2022; 61(5): 548-57 6 Falkenberg C et al.: Basal proliferation and acantholysis may represent histological high-risk factors for progression into invasive squamous cell carcinoma: A comparison study in solid organ transplant recipients and matched immunocompetent patients. Cancers (Basel) 2023; 15(6): 1765 7 Santhosh A et al.: Randomized double-blind, placebo-controlled study of topical diclofenac in the prevention of hand-foot syndrome in patients receiving capecitabine (the D-TORCH study). Trials 2022; 23(1): 420
Das könnte Sie auch interessieren:
Highlights zu Lymphomen
Assoc.Prof. Dr. Thomas Melchardt, PhD zu diesjährigen Highlights des ASCO und EHA im Bereich der Lymphome, darunter die Ergebnisse der Studien SHINE und ECHELON-1
Therapie im Wandel: zeitlich begrenzt und Sequenzierung
Die therapeutische Landschaft der chronischen lymphatischen Leukämie (CLL) hat sich in den vergangenen Jahren fundamental gewandelt. Die klassische Chemoimmun-therapie ist weitgehend ...
Chronische myeloische Leukämie (CML)
Die Prognose der CML-Patient:innen unterscheidet sich durch die Entwicklung der Tyrosinkinaseinhibitoren (TKI) kaum mehr von der Normalbevölkerung. Dennoch gibt es neue Erkenntnisse, die ...